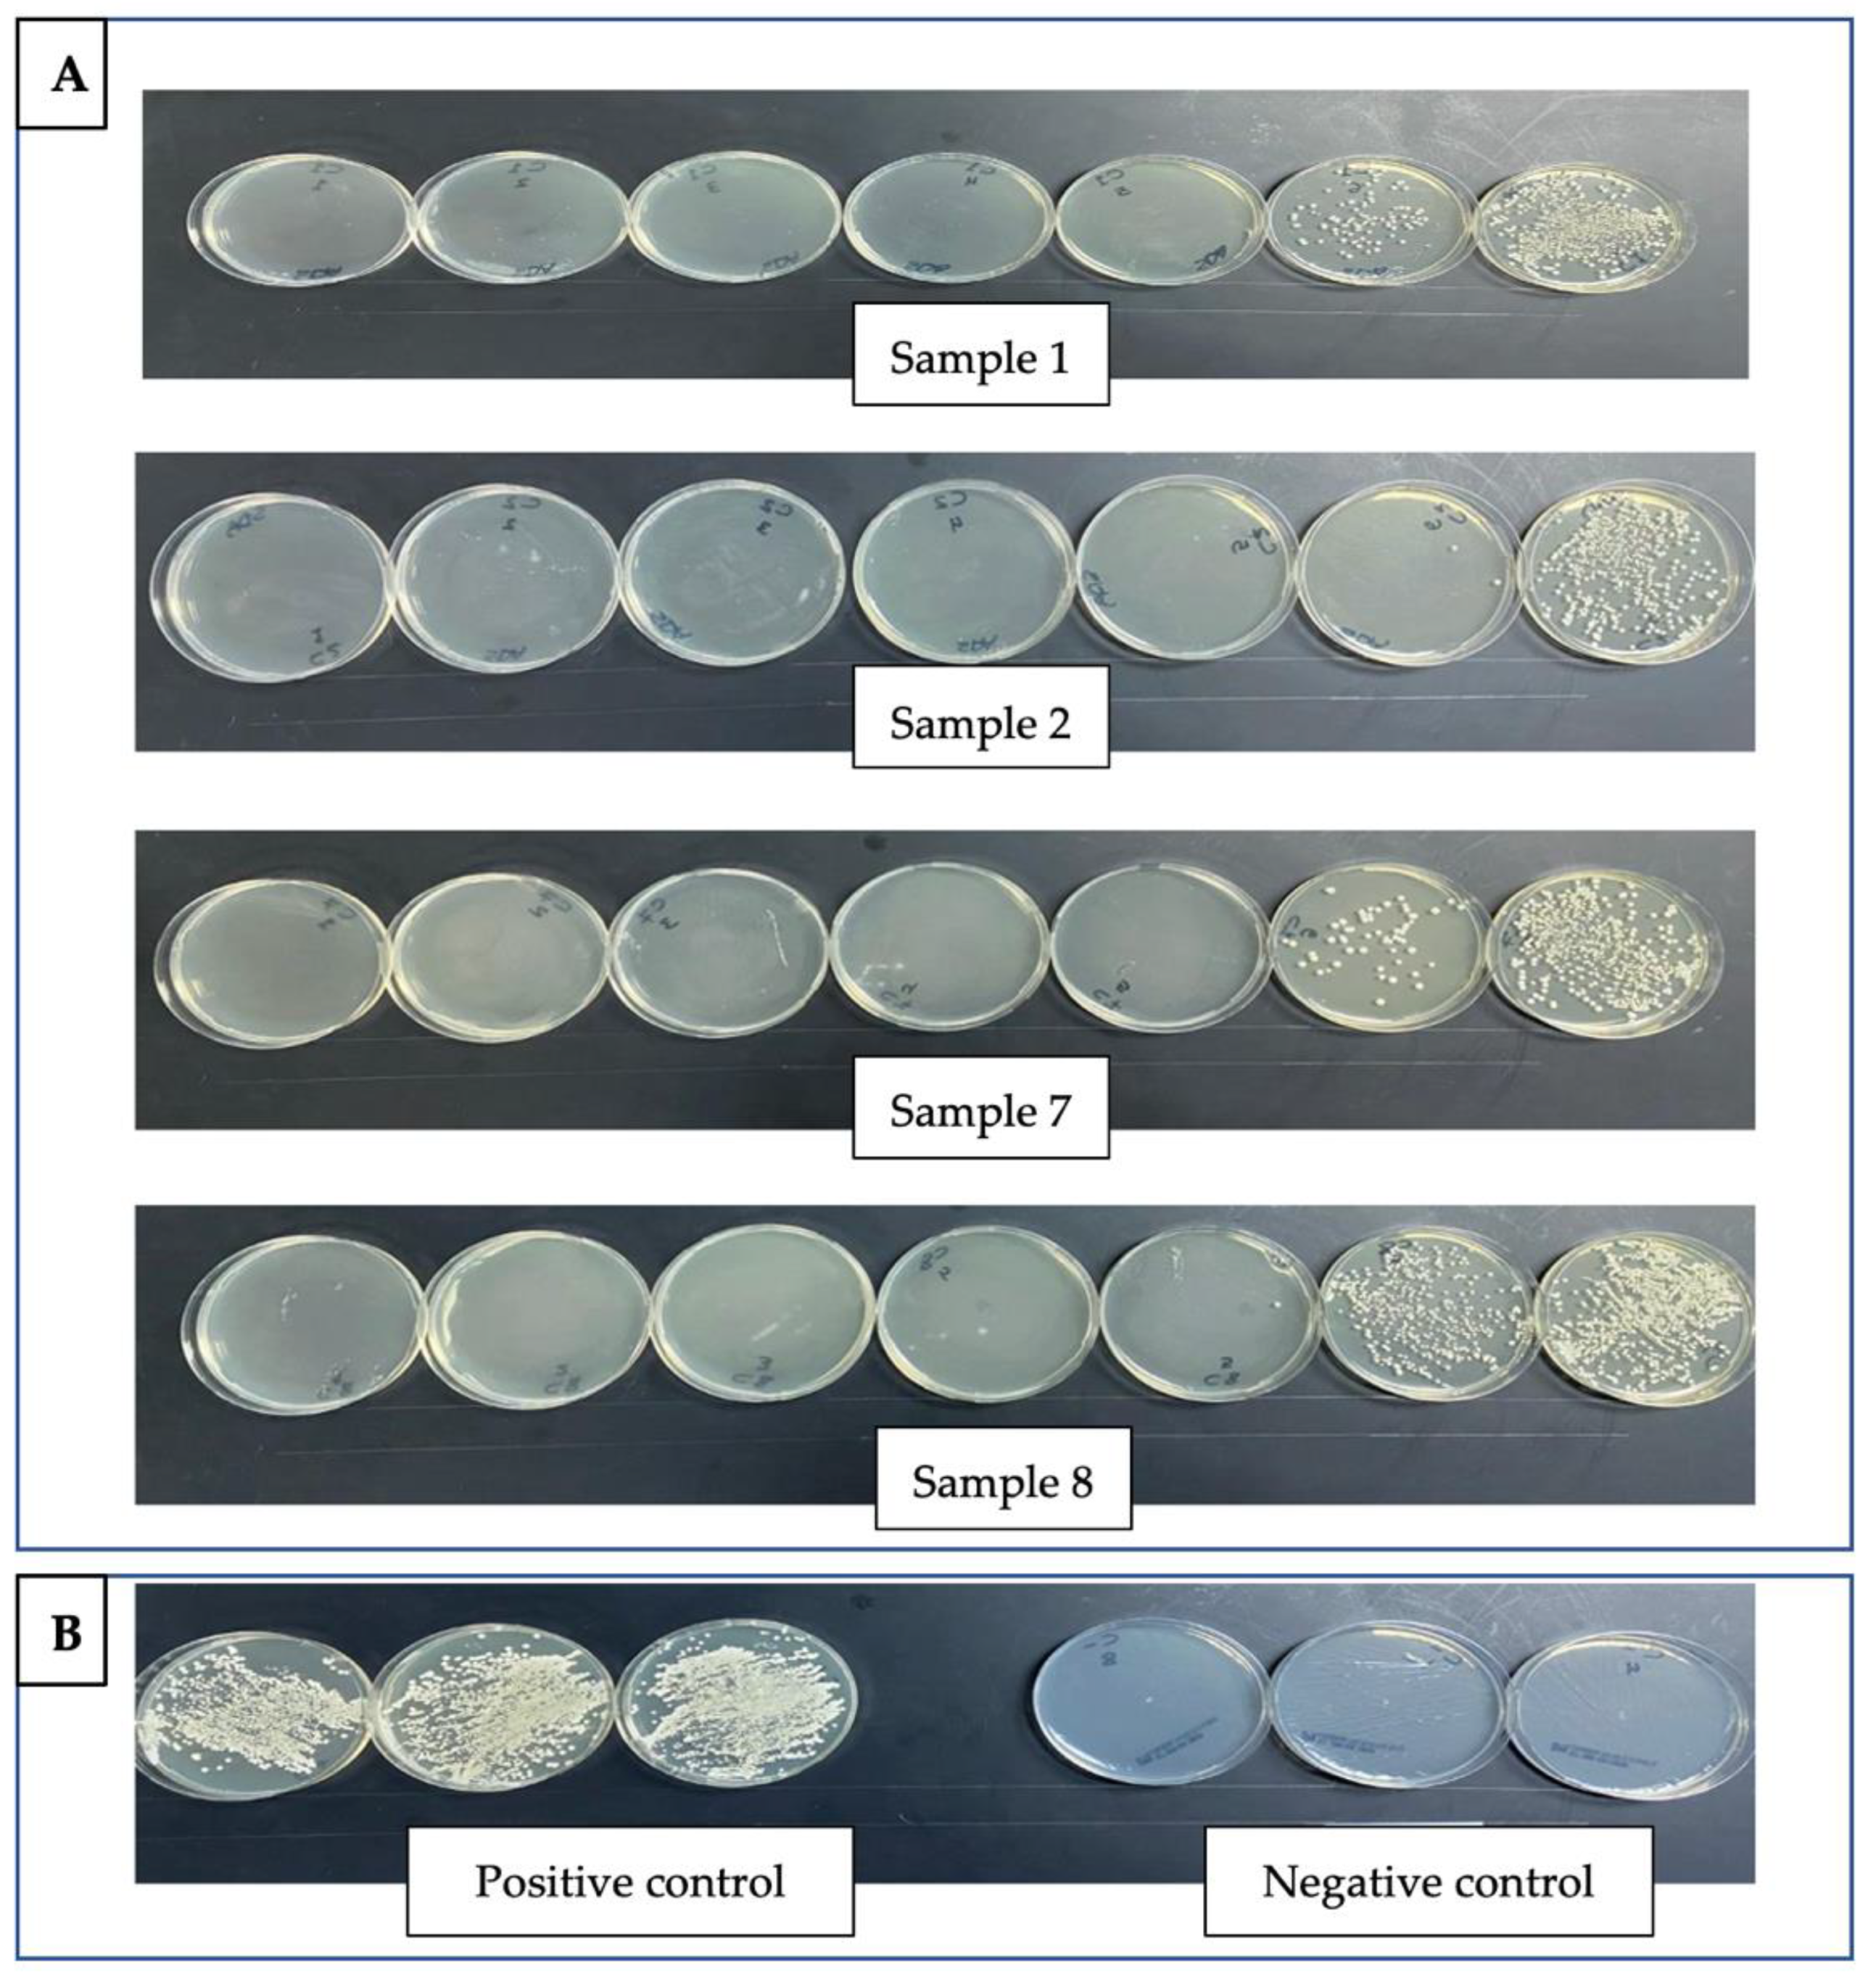

Silver Nanoparticles: A Promising Antifungal Agent against the Growth and Biofilm Formation of the Emergent Candida auris
Abstract
:1. Introduction
2. Materials and Methods
2.1. Ethics Approval
2.2. Collection of Samples and Isolation
2.3. Antifungal Susceptibility Profile
2.4. Silver Nanoparticles Preparation
2.5. Antifungal Susceptibility Testing
2.6. Antibiofilm Activity Evaluation
3. Results
4. Discussion
5. Conclusions
Author Contributions
Funding
Institutional Review Board Statement
Informed Consent Statement
Data Availability Statement
Acknowledgments
Conflicts of Interest
Abbreviations
| C. auris | Candida auris |
| C. albicans | Candida albicans |
| MALDI TOF MS | matrix-assisted laser desorption/ionization-time of flight mass spectrometry |
| IPP | Infection Prevention Program |
| CDC | Centers for Disease Control and prevention |
| ITS | internal transcribed spacer |
References
- Ahmad, A.; Spencer, J.E.; Lockhart, S.R.; Singleton, S.; Petway, D.J.; Bagarozzi, D.A.; Herzegh, O.T. A high-throughput and rapid method for accurate identification of emerging multidrug-resistant Candida auris. Mycoses 2019, 62, 513–518. [Google Scholar] [CrossRef] [PubMed] [Green Version]
- Nett, J.E. Candida auris: An emerging pathogen “incognito”? PLoS Pathog. 2019, 15, 6–11. [Google Scholar] [CrossRef] [PubMed]
- Rossato, L.; Colombo, A.L. Candida auris: What have we learned about its mechanisms of pathogenicity? Front. Microbiol. 2018, 9, 3081. [Google Scholar] [CrossRef]
- Abdalhamid, B.; Almaghrabi, R.; Althawadi, S.; Omrani, A. First report of Candida auris infections from Saudi Arabia. J. Infect. Public Health 2018, 11, 598–599. [Google Scholar] [CrossRef]
- Elsawy, A.; Alquthami, K.; Alkhutani, N.; Marwan, D.; Abbas, A. The second confirmed case of Candida auris from Saudi Arabia. J. Infect. Public Health 2019, 12, 907–908. [Google Scholar] [CrossRef] [PubMed]
- Aljindan, R.; Aleraky, D.M.; Mahmoud, N.; Abdalhamid, B.; Almustafa, M.; Abdulazeez, S.; Francis Borgio, J. Drug resistance-associated mutations in erg11 of multidrug-resistant candida auris in a tertiary care hospital of eastern Saudi Arabia. J. Fungi 2021, 7, 18. [Google Scholar] [CrossRef]
- Horton, M.V.; Nett, J.E. Candida auris Infection and Biofilm Formation: Going Beyond the Surface What Is the Clinical Presentation of C. auris. Curr. Clin. Microbiol. Rep. 2020, 7, 51–56. [Google Scholar] [CrossRef]
- Girard, V.; Mailler, S.; Chetry, M.; Vidal, C.; Durand, G.; van Belkum, A.; Colombo, A.L.; Hagen, F.; Meis, J.F.; Chowdhary, A. Identification and typing of the emerging pathogen Candida auris by matrix-assisted laser desorption ionisation time of flight mass spectrometry. Mycoses 2016, 59, 535–538. [Google Scholar] [CrossRef]
- Chowdhary, A.; Sharma, C.; Meis, J.F. Candida auris: A rapidly emerging cause of hospital-acquired multidrug-resistant fungal infections globally. PLoS Pathog. 2017, 13, e1006290. [Google Scholar] [CrossRef]
- Sherry, L.; Ramage, G.; Kean, R.; Borman, A.; Johnson, E.M.; Richardson, M.D.; Rautemaa-Richardson, R. Biofilm-forming capability of highly virulent, multidrug-resistant Candida auris. Emerg. Infect. Dis. 2017, 23, 328–331. [Google Scholar] [CrossRef] [Green Version]
- Sayeed, M.A.; Farooqi, J.; Jabeen, K.; Mahmood, S.F. Comparison of risk factors and outcomes of Candida auris candidemia with non-Candida auris candidemia: A retrospective study from Pakistan. Med. Mycol. 2020, 58, 721–729. [Google Scholar] [CrossRef] [PubMed]
- Hou, X.; Lee, A.; Jiménez-ortigosa, C.; Kordalewska, M.; Perlin, D.S. Rapid Detection of ERG11-Associated Azole Resistance and FKS-Associated Echinocandin Resistance in Candida auris. Antimicrob. Agents Chemother. 2018, 63, 1–7. [Google Scholar]
- de Cássia Orlandi Sardi, J.; Silva, D.R.; Soares Mendes-Giannini, M.J.; Rosalen, P.L. Candida auris: Epidemiology, risk factors, virulence, resistance, and therapeutic options. Microb. Pathog. 2018, 125, 116–121. [Google Scholar] [CrossRef] [PubMed] [Green Version]
- Das, S.; Tigga, R.; Rai, G.; Singh, P.K.; Datt, S.; Tyagi, A.; Singh, N.P. Candida auris colonization in an immunocompetent patient: A new threat in medical ICU. Med. Mycol. Case Rep. 2018, 21, 54–56. [Google Scholar] [CrossRef]
- Vazquez-Munoz, R.; Lopez, F.D.; Lopez-Ribot, J.L. Silver Nanoantibiotics Display Strong Antifungal Activity Against the Emergent Multidrug-Resistant Yeast Candida auris Under Both Planktonic and Biofilm Growing Conditions. Front. Microbiol. 2020, 11, 1673. [Google Scholar] [CrossRef]
- Vatanshenassan, M.; Boekhout, T.; Meis, J.F.; Berman, J.; Chowdhary, A.; Ben-Ami, R.; Sparbier, K.; Kostrzewa, M. Candida auris identification and rapid antifungal susceptibility testing against echinocandins by MALDI-TOF MS. Front. Cell. Infect. Microbiol. 2019, 9, 20. [Google Scholar] [CrossRef] [PubMed] [Green Version]
- Duyvejonck, H.; Cools, P.; Decruyenaere, J.; Roelens, K.; Noens, L.; Vermeulen, S.; Claeys, G.; Decat, E.; Van Mechelen, E.; Vaneechoutte, M. Validation of High Resolution Melting Analysis (HRM) of the amplified ITS2 region for the detection and identification of yeasts from clinical samples: Comparison with culture and MALDI-TOF based identification. PLoS ONE 2015, 10, e0132149. [Google Scholar] [CrossRef]
- Antifungal Susceptibility Testing and Interpretation | Candida Auris | Fungal Diseases | CDC. Available online: https://www.cdc.gov/fungal/candida-auris/c-auris-antifungal.html (accessed on 29 November 2020).
- Pal, A.; Shah, S.; Devi, S. Microwave-assisted synthesis of silver nanoparticles using ethanol as a reducing agent. Mater. Chem. Phys. 2009, 114, 530–532. [Google Scholar] [CrossRef]
- Clinical and Laboratory Standards Institute (CLSI). Reference method for broth dilution. In Reference Method for Broth Dilution Antifungal Susceptibility Testing of Yeasts; Approved Standard Yeasts Standard, 3rd ed.; CLSI: Wayne, PA, USA, 2008; Volume 28, p. 13. [Google Scholar]
- Balouiri, M.; Sadiki, M.; Ibnsouda, S.K. Methods for in vitro evaluating antimicrobial activity: A review. J. Pharm. Anal. 2016, 6, 71–79. [Google Scholar] [CrossRef] [Green Version]
- Shichiri-Negoro, Y.; Tsutsumi-Arai, C.; Arai, Y.; Satomura, K.; Arakawa, S.; Wakabayashi, N. Ozone ultrafine bubble water inhibits the early formation of Candida albicans biofilms. PLoS ONE 2021, 16, e0261180. [Google Scholar] [CrossRef]
- Kwolek-Mirek, M.; Zadrag-Tecza, R. Comparison of methods used for assessing the viability and vitality of yeast cells. FEMS Yeast Res. 2014, 14, 1068–1079. [Google Scholar] [CrossRef] [PubMed]
- Spivak, E.S.; Hanson, K.E. Candida auris: An Emerging Fungal Pathogen. J. Clin. Microbiol. 2018, 56, e01588-17. [Google Scholar] [CrossRef] [PubMed] [Green Version]
- Osei Sekyere, J. Candida auris: A systematic review and meta-analysis of current updates on an emerging multidrug-resistant pathogen. Microbiologyopen 2018, 7, e00578. [Google Scholar] [CrossRef] [Green Version]
- Vallabhaneni, S.; Kallen, A.; Tsay, S.; Chow, N.; Welsh, R.; Kerins, J.; Kemble, S.K.; Pacilli, M.; Black, S.R.; Landon, E.; et al. Investigation of the First Seven Reported Cases of Candida auris, a Globally Emerging Invasive, Multidrug-Resistant Fungus—United States, May 2013–August 2016. Am. J. Transplant. 2017, 17, 296–299. [Google Scholar] [CrossRef] [PubMed]
- Abanamy, H.; Alsharif, T.; Solomon, R.; AlAlwan, A.-J.S. Reporting 4 Candida auris in National Guard Hospital, Riyadh/ Saudi Arabia- ClinicalKey. J. Infect. Public Heal. 2019, 12, 139–140. [Google Scholar] [CrossRef]
- Khan, Z.; Ahmad, S.; Benwan, K.; Purohit, P.; Al-Obaid, I.; Bafna, R.; Emara, M.; Mokaddas, E.; Abdullah, A.A.; Al-Obaid, K.; et al. Invasive Candida auris infections in Kuwait hospitals: Epidemiology, antifungal treatment and outcome. Infection 2018, 46, 641–650. [Google Scholar] [CrossRef]
- Mohsin, J.; Hagen, F.; Al-Balushi, Z.A.M.; de Hoog, G.S.; Chowdhary, A.; Meis, J.F.; Al-Hatmi, A.M.S. The first cases of Candida auris candidaemia in Oman. Mycoses 2017, 60, 569–575. [Google Scholar] [CrossRef] [Green Version]
- Al-Siyabi, T.; Al Busaidi, I.; Balkhair, A.; Al-Muharrmi, Z.; Al-Salti, M.; Al’Adawi, B. First report of Candida auris in Oman: Clinical and microbiological description of five candidemia cases. J. Infect. 2017, 75, 373–376. [Google Scholar] [CrossRef]
- Gulati, M.; Lohse, M.B.; Ennis, C.L.; Gonzalez, R.E.; Perry, A.M.; Bapat, P.; Arevalo, A.V.; Rodriguez, D.L.; Nobile, C.J. In Vitro Culturing and Screening of Candida albicans Biofilms. Curr. Protoc. Microbiol. 2018, 50, e60. [Google Scholar] [CrossRef]
- Jaswal, T.; Gupta, J. A review on the toxicity of silver nanoparticles on human health. Mater. Today Proc. 2021. [Google Scholar] [CrossRef]
- Tortella, G.R.; Rubilar, O.; Durán, N.; Diez, M.C.; Martínez, M.; Parada, J.; Seabra, A.B. Silver nanoparticles: Toxicity in model organisms as an overview of its hazard for human health and the environment. J. Hazard. Mater. 2020, 390, 121974. [Google Scholar] [CrossRef] [PubMed]
- Gibała, A.; Żeliszewska, P.; Gosiewski, T.; Krawczyk, A.; Duraczyńska, D.; Szaleniec, J.; Szaleniec, M.; Oćwieja, M. Antibacterial and antifungal properties of silver nanoparticles—effect of a surface-stabilizing agent. Biomolecules 2021, 11, 1481. [Google Scholar] [CrossRef] [PubMed]

| Antifungal Susceptibility of C. auris MIC (ug/mL) | ||||||||
|---|---|---|---|---|---|---|---|---|
| Antifungal Agents | Sample 1 | Sample 2 | Sample 3 | Sample 4 | Sample 5 | Sample 6 | Sample 7 | Sample 8 |
| Amphotericin B | 0.5 | 0.25 | 8 | 0.5 | 8 | 0.5 | 8 | 0.5 |
| Fluconazole | 16 | 16 | 32 | 32 | 32 | 32 | 32 | 8 |
| Voriconazole | 0.5 | 1 | 0.5 | 0.5 | 1 | 1 | 1 | 8 |
| Caspofungin | 0.25 | 0.25 | 0.25 | 0.25 | 0.25 | 0.25 | 0.25 | 0.25 |
| Micafungin | 0.06 | 0.06 | 0.06 | 0.06 | 0.06 | 0.06 | 0.06 | 0.06 |
| Flucytosine | 1 | 1 | 1 | 1 | 1 | 1 | 1 | 1 |
Publisher’s Note: MDPI stays neutral with regard to jurisdictional claims in published maps and institutional affiliations. |
© 2022 by the authors. Licensee MDPI, Basel, Switzerland. This article is an open access article distributed under the terms and conditions of the Creative Commons Attribution (CC BY) license (https://creativecommons.org/licenses/by/4.0/).
Share and Cite
AlJindan, R.; AlEraky, D.M. Silver Nanoparticles: A Promising Antifungal Agent against the Growth and Biofilm Formation of the Emergent Candida auris. J. Fungi 2022, 8, 744. https://doi.org/10.3390/jof8070744
AlJindan R, AlEraky DM. Silver Nanoparticles: A Promising Antifungal Agent against the Growth and Biofilm Formation of the Emergent Candida auris. Journal of Fungi. 2022; 8(7):744. https://doi.org/10.3390/jof8070744
Chicago/Turabian StyleAlJindan, Reem, and Doaa M. AlEraky. 2022. "Silver Nanoparticles: A Promising Antifungal Agent against the Growth and Biofilm Formation of the Emergent Candida auris" Journal of Fungi 8, no. 7: 744. https://doi.org/10.3390/jof8070744
APA StyleAlJindan, R., & AlEraky, D. M. (2022). Silver Nanoparticles: A Promising Antifungal Agent against the Growth and Biofilm Formation of the Emergent Candida auris. Journal of Fungi, 8(7), 744. https://doi.org/10.3390/jof8070744
